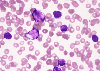

|    |

全登録症例数:225
全登録画像数:1755
全登録画像数:1755
本例は形態像よりALLを考えたが、表現型にてCD3が陰性、CD7が陽性、CD56が陽性、TCR遺伝子を認めなかったことから未熟なNK細胞性腫瘍(Blastic NK-cell lymphoma)を疑った。
さらにCD34の陽性は未分化を示唆す...
(続きを読む) 本例は形態像よりALLを考えたが、表現型にてCD3が陰性、CD7が陽性、CD56が陽性、TCR遺伝子を認めなかったことから未熟なNK細胞性腫瘍(Blastic NK-cell lymphoma)を疑った。
さらにCD34の陽性は未分化を示唆するものであり、NK前駆細胞に骨髄系抗原(CD33)を有することより、Myeloid/NK cell precursor acute leukemiaも示唆するものと思われた。
(たたむ)
さらにCD34の陽性は未分化を示唆す...
(続きを読む) 本例は形態像よりALLを考えたが、表現型にてCD3が陰性、CD7が陽性、CD56が陽性、TCR遺伝子を認めなかったことから未熟なNK細胞性腫瘍(Blastic NK-cell lymphoma)を疑った。
さらにCD34の陽性は未分化を示唆するものであり、NK前駆細胞に骨髄系抗原(CD33)を有することより、Myeloid/NK cell precursor acute leukemiaも示唆するものと思われた。
(たたむ)
■症例詳細データ
| 性別 | 男 |
|---|---|
| 年齢 | 30-34 |
| 取得年代 | 2000-2004 |
| 症例の種類 | 典型例 |
| 主訴 | 汎血球減少症 |
| 既往歴 | 特になし |
| 現病歴 | 皮膚病変、リンパ節腫脹 |
| 検査所見 | RBC 324万/μl、Hb 10.5g/dl、Ht 30.6%、MCV 94.4fl、MCH 32.4pg、MCHC 34.3%、PLT 5.4万/μl WBC 2,200/μl、NCC 20.6万/μl、LD 684U/l、EBV (-) |
| 末梢血所見 | 白血球減少(2,200/μl)にて芽球様が52%みられた。それらは大型でN/C比は高く、 核形不整がみられ、クロマチンは粗鋼で、細胞質の好塩基性は辺縁に強い傾向がみられた。 アズール顆粒は認めなかった。 |
| 骨髄所見 | 正形成像で芽球様は86%みられたが、周囲には核影がみられたため芽球はさらに増すものと思われた。芽球様は形態からリンパ系を疑うものであった。 |
| 細胞化学所見 | 芽球様はPO染色、PAS染色にて陰性であった。 |
| 形態診断 | 末梢血、骨髄に増加するリンパ系の芽球様は20%以上であることからALLを疑った。これらの芽球の起源を決定づけるには表現型が気になるところである。 |
| 免疫学的所見 | CD3-, CD4+, CD7+, CD33+, CD34+, CD43+, CD56+ |
| 分子生物学的所見 | 46,XY TCR遺伝子(-) |
| リンパ節所見 | 腫瘍細胞の増殖はリンパ系を思わせ、免疫染色にてCD56が陽性であった。 |
| 臨床診断 | 形態像よりALLを考えたが、表現型にてCD3が陰性、CD7が陽性、CD56が陽性、TCR遺伝子を認めなかったことから未熟なNK細胞性腫瘍(Blastic NK-cell lymphoma)を疑った。 さらにCD34の陽性は未分化を示唆するものであり、NK前駆細胞に骨髄系抗原(CD33)を有することより、Myeloid/NK cell precursor acute leukemiaも示唆するものと思われた。 |